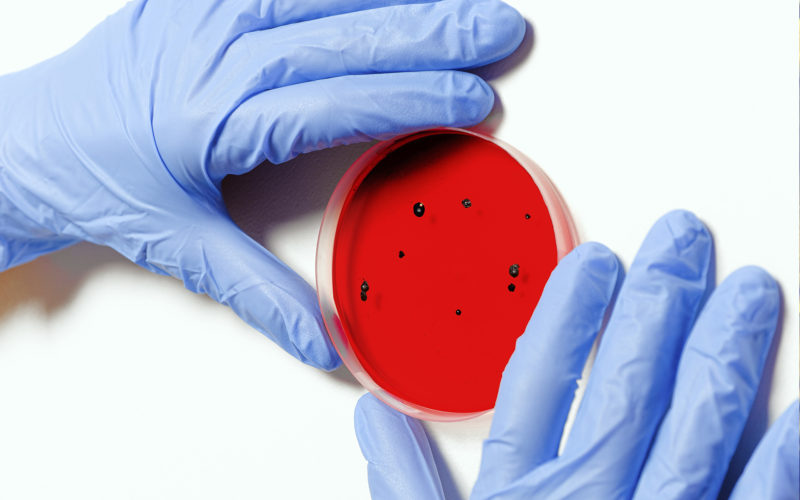

El Centro de Sostenibilidad y Liderazgo Responsable inicia actividad en Panamá
Este Centro de ámbito internacional, promovido por la escuela de negocios IESA, ubica a Panamá en una posición de liderazgo en materia de formación, investigación, difusión y consultoría, en un tema fundamental en nuestros tiempos como lo es la sostenibilidad y permitirá acompañar a las organizaciones y sus líderes en la transición hacia una nueva economía global, más…